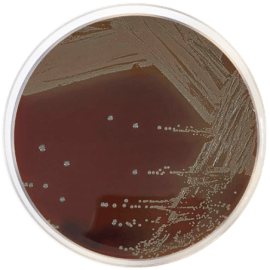
main product photo

Close
EUGON AGAR 500 grams/bottle
SKU
CDL/1036
Brand
CONDALAB
Pre-order (Deliver in 8 to 12 weeks)
Eugon Agar is a medium recommended for the growth of a wide variety of microorganisms. It yields a high level of growth of microorganisms (eugonic growth) even with bacteria which are more difficult to cultivate, such as Haemophilus, Neisseria, Pasteurella, Brucella, Lactobacillus, etc. It is very useful in medical bacteriology and food testing, such as cured meat, dairy products and other foods. Likewise, this medium is ideal for cultivating delicate pathogenic microorganisms and for obtaining high counts of bacterial cultures in the preparation of antigens and vaccines.
L-Cystine and sodium sulfite are added to stimulate growth. Casein and soy peptones provide nitrogen, vitamins, minerals and amino acids essential for growth. Dextrose is the fermentable carbohydrate providing carbon and energy. Sodium chloride supplies essential electrolytes for transport and osmotic balance. Bacteriological agar is the solidifying agent. The addition of blood provides extra growth factors for fastidious microorganisms and the Polyenrichment supplement (Cat. 6011) is a supplement specifically formulated for Neisseria, Francisella and Brucella.
The non-enriched medium is recommended for the rapid growth of lactobacilli linked to cured meat products, dairy products and other foods.
The addition of defibrinated blood, chocolated or not, permits the development of Histoplasma capsulatum and Nocardia. The medium also is used for the analysis of clinical materials such as blood and cerebrospinal or pleural fluids that generally contain pure cultures.
Eugon Agar is a medium recommended for the growth of a wide variety of microorganisms. It yields a high level of growth of microorganisms (eugonic growth) even with bacteria which are more difficult to cultivate, such as Haemophilus, Neisseria, Pasteurella, Brucella, Lactobacillus, etc. It is very useful in medical bacteriology and food testing, such as cured meat, dairy products and other foods. Likewise, this medium is ideal for cultivating delicate pathogenic microorganisms and for obtaining high counts of bacterial cultures in the preparation of antigens and vaccines.
L-Cystine and sodium sulfite are added to stimulate growth. Casein and soy peptones provide nitrogen, vitamins, minerals and amino acids essential for growth. Dextrose is the fermentable carbohydrate providing carbon and energy. Sodium chloride supplies essential electrolytes for transport and osmotic balance. Bacteriological agar is the solidifying agent. The addition of blood provides extra growth factors for fastidious microorganisms and the Polyenrichment supplement (Cat. 6011) is a supplement specifically formulated for Neisseria, Francisella and Brucella.
The non-enriched medium is recommended for the rapid growth of lactobacilli linked to cured meat products, dairy products and other foods.
The addition of defibrinated blood, chocolated or not, permits the development of Histoplasma capsulatum and Nocardia. The medium also is used for the analysis of clinical materials such as blood and cerebrospinal or pleural fluids that generally contain pure cultures.
| Brand | CONDALAB |
|---|
Write Your Own Review

Validate your login